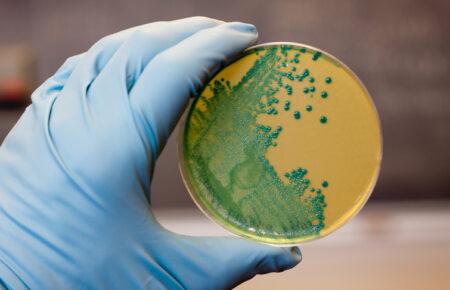
Cтійкі до ліків бактерії можуть поширюватися від людей до диких тварин

Здоров'я
Обрати рубрику


У Британії тестують першу у світі інʼєкцію, яка запобігатиме розвитку раку шкіри

Cтійкі до ліків бактерії можуть поширюватися від людей до диких тварин

Вакцину проти вірусу папіломи людини у майбутньому включать до календаря щеплень

Близько 99% людей, які померли внаслідок грипу і COVID-19, не були вакциновані — Ігор Кузін

Якщо їсти лише салат, буде схильність до надміру розмноження бактерій – Тетяна Лакуста

Кому і коли потрібно вакцинуватися проти гепатиту: пояснює лікарка-інфекціоністка

Що не слід говорити дружинам військових?

Харківська волонтерська ініціатива «CodeIT4Life» створила третій мобільний шпиталь для бойових медиків

Як уникнути контакту зі зміями, та що робити, якщо вас вкусили — пояснює молодший науковий співробітник Інституту зоології

Фізична активність допомагає зменшити тривогу

Перукарня і психологи: як працює соціальний центр у Бородянці після окупації

З авокадо і без: як змінився збірник рецептів для шкіл від Клопотенка

«База»: як працює безоплатний застосунок психологічної підтримки

Війна змусила нас замислитись, що люди з інвалідністю повинні активно жити в соціумі — Уляна Пчолкіна

Як боротися з пилковою алергією

Як в Україні працюють добровільні пожежні команди

Силові вправи важливіші за гнучкість — повітряна акробатка

Лише 73% дітей торік вакцинуватися від кашлюку — Тимко-Іванченко